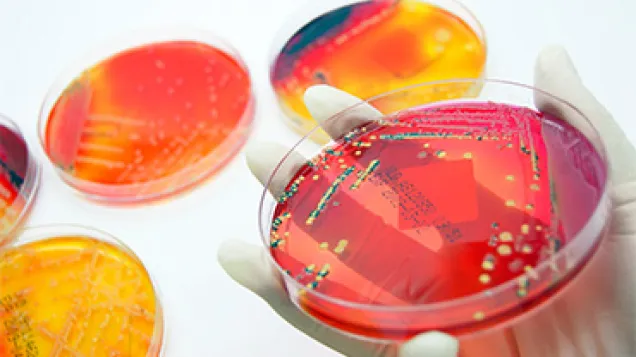
Bacteria in Petri dish. © Istock

Public health topics
Public health topics
Diseases A-Z
A
B
C
- Campylobacteriosis
- Chickenpox (varicella)
- Chikungunya virus disease
- Chlamydia infection
- Cholera
- Ciguatera fish poisoning (CFP)
- Clostridioides difficile infections
- Congenital rubella
- Congenital syphilis
- Coronavirus
- COVID-19
- Coxsackievirus
- Creutzfeldt-Jakob disease (CJD)
- Crimean-Congo haemorrhagic fever (CCHF)
- Cryptosporidiosis
- Cutaneous warts
D
E
F
G
H
I
J
L
M
N
O
P
Q
R
S
- S. pneumoniae
- Salmonellosis
- SARS-CoV-2
- Seasonal influenza
- Severe acute respiratory syndrome (SARS)
- Sexually transmitted infections
- Shiga toxin producing Escherichia coli (STEC) infection
- Shigellosis
- Sindbis fever
- Smallpox
- Streptococcus pneumoniae
- Substances of human origin
- Sustainable Development Goals (SDGs)
- Swine-origin influenza
- Syphilis
- Syphilis, congenital